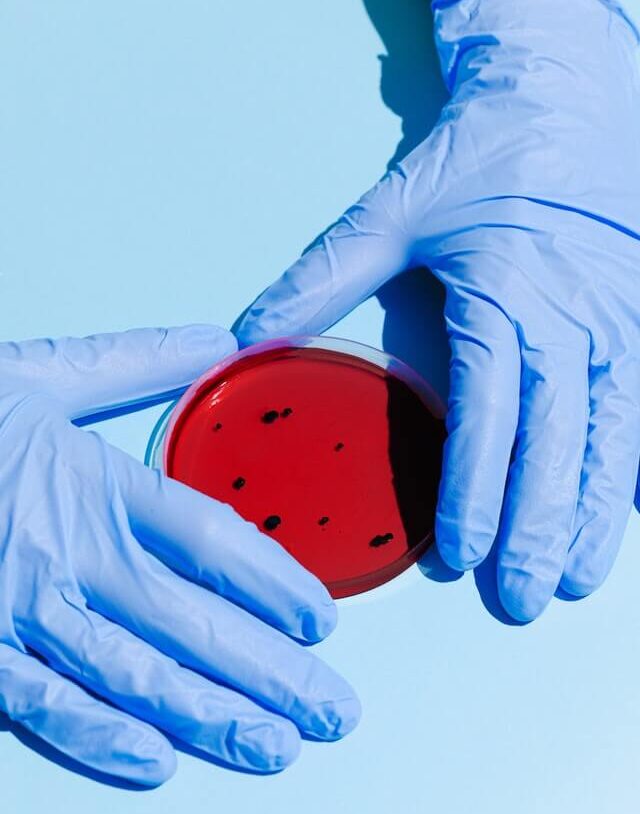

More Than a Lab — Your Partner in Health
Providing accurate diagnostics for informed health decisions.
At 24hr DiagnoLabs, we don’t just process samples — we walk with you on your health journey. From first symptoms to treatment decisions, we provide reliable results, expert support, and compassionate service that empowers you and your doctor every step of the way.

Why Choose Us
Vision
To become the service provider of choice in the provision of Evidence based diagnosis in Zimbabwe and beyond, meanwhile enhancing sustainable relationships with our stakeholders.
Mission
To provide accurate medical testing that empowers patients and clinicians with reliable, dependable and timely access to healthcare solutions.
Principles & Ethics
24hr Diagnolabs is commited to the principles of openness, Integrity and accountability in its dealings with all its customers
